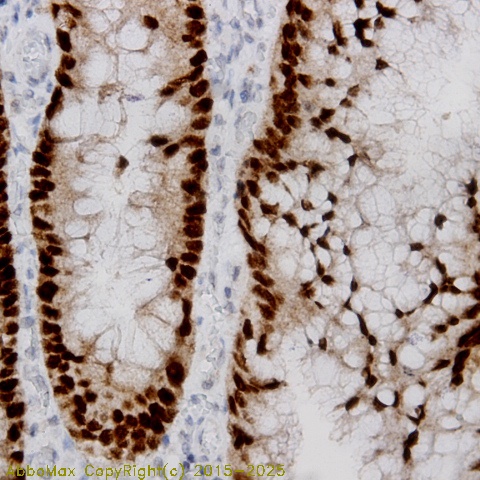

Cdk9
cyclin-dependent kinase 9
 Download Product PDF
Download Product PDF
 MSDS Download Product PDF
MSDS Download Product PDF
Antigen Preparation
A synthetic peptide corresponding to the C-terminus of mouse PLAC1 protein (from 145aa-175aa). This sequence is identical to human, rat and mouse
Background
"CDK9 belongs to a member of the cyclin-dependent protein kinase (CDK) family. It is also known as an important cell cycle regulator. This kinase was found to be a component of the multiprotein complex TAK/P-TEFb, which is an elongation factor for RNA polymerase II-directed transcription and functions by phosphorylating the C-terminal domain of the largest subunit of RNA polymerase II. The CDK9 C-terminal tail sequence is important for the catalytic mechanism and imposes an ordered binding of substrates and release of products. It is regulated by the phosphorylation of CDK9 at Thr 29, Thr186. "
PURIFICATION
The Rabbit IgG is purified by Epitope Affinity Purification
|
SPECIFICITY
"This antibody recognizes Cdk9 protein. It cross-reacts to human, rat and mouse. The other species are not tested. "
|
FORMULATION
This affinity purified antibody is supplied in sterile Phosphatebuffered saline (pH7.2) containing antibody stabilizer
|
STORAGE
The antibodies are stable for 24 months from date of receipt when stored at –20oC to –70oC. The antibodies can be stored at 2oC-8oC for three month without detectable loss of activity. Avoid repeated freezing-thawing cycles.
|
Applications/Suggested Working Dilutions
|
|
|
Immunoprecipitation
2-5 µg/ml
|
|
Flow cytometry
Not tested
|